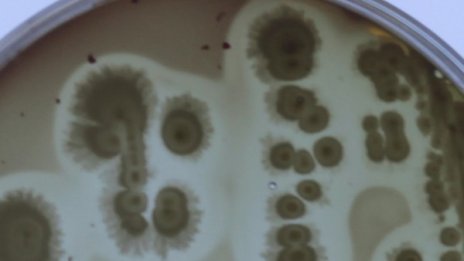
Животът може да е възникнал под земята

Новини
-
Президентът Йотова: ЕС може да постигне стратегическа автономия
-
Иван Шишков: Северна България е с най-лоша пътна мрежа
-
Бургери, газирано, венозна недостатъчност, а Тръмп е в... отлично здраве
-
Делото срещу Тимошенко за подкуп на депутати е внесено в съда
-
Real Estate Awards 2025 ще отличи добрите практики в имотния сектор
-
Мицкоски твърд: РСМ няма да прави конституционни промени, ще си платим цената
-
Творци наемат външни консултанти за проекти в сектор "Култура"
-
Руското посолство у нас: Днес почитаме създателите на първата славянска азбука
-
Старо интервю на Слави Трифонов с Дара предизвика възмущение онлайн ВИДЕО
-
Има опити за посегателства върху държавността ни от либерално-демократичното виждане
-
Тежко престъпление е по-вероятната версия за трагедията в Благоевград?
-
Украйна използва цивилни, майки и таксиметрови шофьори, за да свалят руски дронове
-
Никола Цолов: Предателство е единствената правилна дума за чувствата ми в момента
-
Демерджиев обяви чистка в МВР и безкомпромисна борба с нарушенията в системата
-
Философията на Дугин: Руснаците не са войнствен народ, живеят мирно в окопите
-
Тук не е за бедни: Пицата в София е 13 евро, колкото в Люксембург
-
Станаха лукс: Българите масово купуват по 100–300 грама череши, само за опитване ВИДЕО
-
Руското посолство у нас: Днес почитаме създателите на първата славянска азбука
-
Лавров уведомил САЩ: Русия започва последователни удари по обекти в Киев
-
Тайният руски проект "Скити": ядрени ракети на морското дъно
-
ДБ питат Радев: Русия агресор ли е срещу Украйна?

Новият председател на Фед е обречен да се разграничи от предизборното си послание
Новият председател на Фед е обречен да се разграничи от предизборното си послание  БНБ промени наредбата за капиталовите буфери
БНБ промени наредбата за капиталовите буфери  Xiaomi цели разрастване на чуждестранните пазари на фона на растящите разходи и конкуренцията
Xiaomi цели разрастване на чуждестранните пазари на фона на растящите разходи и конкуренцията  С нови проекти ще се строят Околовръстният път на Пловдив и каскадата Доспат - Въча
С нови проекти ще се строят Околовръстният път на Пловдив и каскадата Доспат - Въча  ЕЦБ: Еврозоната не е застрашена от системен риск, но частното кредитиране създава напрежение
ЕЦБ: Еврозоната не е застрашена от системен риск, но частното кредитиране създава напрежение  Мобилното приложение за дигитални карти за градския транспорт в София тръгва тестово
Мобилното приложение за дигитални карти за градския транспорт в София тръгва тестово 
 Костадинов със съболезнования до Митрофанова и писмо до Радев
Костадинов със съболезнования до Митрофанова и писмо до Радев  Мицкоски: Няма да променяме Конституцията на РСМ заради България
Мицкоски: Няма да променяме Конституцията на РСМ заради България  Гореща вълна в Европа - хората търсят спасение от жегите (СНИМКИ)
Гореща вълна в Европа - хората търсят спасение от жегите (СНИМКИ)  Йотова пред посланици: ЕС има потенциал за стратегическа автономия и водеща роля
Йотова пред посланици: ЕС има потенциал за стратегическа автономия и водеща роля  Христо Мутафчиев пита спешно за съкращения в театрите
Христо Мутафчиев пита спешно за съкращения в театрите  Шойгу: НАТО отработва сценарии за удари по Русия и Беларус
Шойгу: НАТО отработва сценарии за удари по Русия и Беларус 
 Карла Жинола
Карла Жинола  Почна ги: Сабаленка гази на „Ролан Гарос“
Почна ги: Сабаленка гази на „Ролан Гарос“  Сдружение „ПФК Ботев“ изригна заради „Колежа“
Сдружение „ПФК Ботев“ изригна заради „Колежа“  Става страшно: От ЦСКА изреваха мощно за касапницата в Разград
Става страшно: От ЦСКА изреваха мощно за касапницата в Разград  ЦСКА с голяма новина за ветераните на армейците
ЦСКА с голяма новина за ветераните на армейците  Нагелсман с ключов ход преди Мондиал 2026
Нагелсман с ключов ход преди Мондиал 2026 
 Как четенето променя начина, по който виждате света
Как четенето променя начина, по който виждате света  Най-цветното място в България оживява това лято край София
Най-цветното място в България оживява това лято край София  Любовен хороскоп за юни 2026
Любовен хороскоп за юни 2026  Цветове и графити: Louis Vuitton представи круизната си колекция за 2027 (+Снимки)
Цветове и графити: Louis Vuitton представи круизната си колекция за 2027 (+Снимки)  Задължителни подавки за Черешова задушница
Задължителни подавки за Черешова задушница  5 прически с минимална поддръжка
5 прически с минимална поддръжка 
 продава, Парцел, 600 m2 Пловдив област, с.Първенец, 37000 EUR
продава, Парцел, 600 m2 Пловдив област, с.Първенец, 37000 EUR  продава, Парцел, 498 m2 Пловдив област, гр.Куклен, 57500 EUR
продава, Парцел, 498 m2 Пловдив област, гр.Куклен, 57500 EUR  продава, Двустаен апартамент, 61 m2 Пловдив, Христо Смирненски, 94999 EUR
продава, Двустаен апартамент, 61 m2 Пловдив, Христо Смирненски, 94999 EUR  продава, Парцел, 600 m2 Пловдив област, с.Белащица, 79900 EUR
продава, Парцел, 600 m2 Пловдив област, с.Белащица, 79900 EUR  продава, Къща, 154 m2 Пловдив област, с.Труд, 119999 EUR
продава, Къща, 154 m2 Пловдив област, с.Труд, 119999 EUR  продава, Тристаен апартамент, 108 m2 Пазарджик, Устрем, 130000 EUR
продава, Тристаен апартамент, 108 m2 Пазарджик, Устрем, 130000 EUR 
 Нови американски удари в Иран, Техеран обяви, че ще отвърне
Нови американски удари в Иран, Техеран обяви, че ще отвърне  Акция в местност край Варна разкри мащабно незаконно строителство върху 100 дка
Акция в местност край Варна разкри мащабно незаконно строителство върху 100 дка  Йотова: ЕС може да постигне стратегическа автономия и да върне лидерската си роля
Йотова: ЕС може да постигне стратегическа автономия и да върне лидерската си роля  Издирват се две деца от Варна, в неизвестност са от 24 май
Издирват се две деца от Варна, в неизвестност са от 24 май  Лавров предупредил Рубио за удари по Киев
Лавров предупредил Рубио за удари по Киев  Полицията иззе автомобил след катастрофа с пиян шофьор край Варна
Полицията иззе автомобил след катастрофа с пиян шофьор край Варна 
 Астробиолози предлагат използването на AI в търсенето на извънземен живот
Астробиолози предлагат използването на AI в търсенето на извънземен живот  Гъби могат да превърнат лунната почва в плодородна земя
Гъби могат да превърнат лунната почва в плодородна земя  Как Хеопсовата пирамида устоява на земетресения в продължение на хилядолетия?
Как Хеопсовата пирамида устоява на земетресения в продължение на хилядолетия?  Доказано: Хората наистина имат „трето око“ и ето къде се намира то
Доказано: Хората наистина имат „трето око“ и ето къде се намира то  „Дронове глухарчета“ могат да картографират подземните лавови тунели на Марс
„Дронове глухарчета“ могат да картографират подземните лавови тунели на Марс  Ще ни позволи ли медицината да „надхитрим смъртта“?
Ще ни позволи ли медицината да „надхитрим смъртта“?